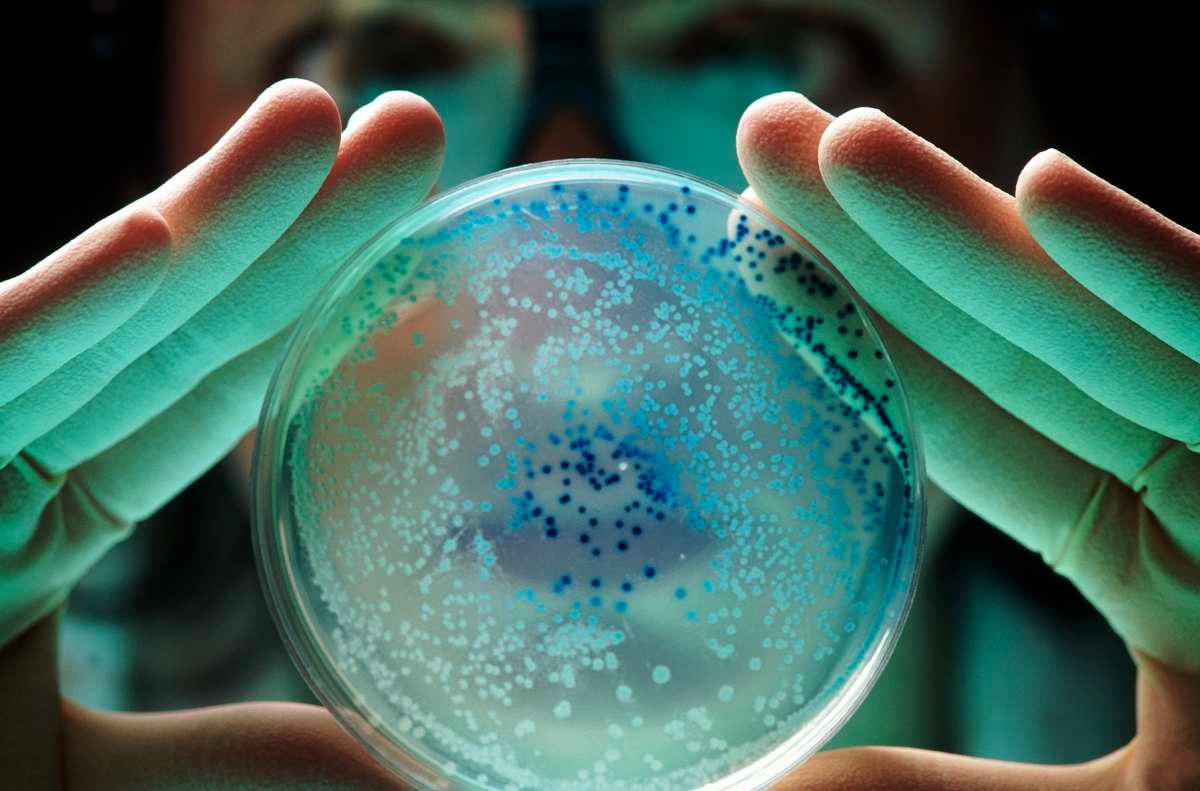
pn/ d e ae cfefca

Microbes Pulled Out From Yellowstone’s Thermal Springs Had Stunning Clues About Origin of Life
Published Sept. 28 2025, 8:45 a.m. ET

Two scientists are examining a hot spring in Yellowstone National Park.
Around 4 billion years ago, there was no Earth, just a gigantic cloud of dust and gas, hovering around the young Sun. Thanks to countless crashes and collisions, the cloud finally collapsed under its own gravity and formed what we call today as home today. At this time, the Sun split the water molecules into oxygen and hydrogen, per the American Society for Microbiology.

Earliest bacteria on Earth billions of years ago
The molecules of oxygen quickly latched onto methane molecules and got trapped inside Earth’s crust, disappearing from the atmosphere. Over the next few years, a mysterious entity secretly worked on unlocking this oxygen from the crust little by little, until there was an explosion. Interestingly, some microbes swimming inside Yellowstone's hot springs hold fascinating clues about this explosive event that transformed the picture of the planet. In a new study published in the journal Nature Communications in January 2025, scientists studied microbes in two hot springs to unravel the mystery of all creation.

Norris Geyser Basin, hot spring in Yellowstone National Park
The research, titled “Respiratory processes of early-evolved hyperthermophiles in sulfidic and low-oxygen geothermal microbial communities,” documents the mystery of the “Great Oxidation Event (GOE)” that unleashed a wellspring of oxygen into Earth’s atmosphere about 2.4 billion years ago. The event happened as a result of the efforts of this mysterious entity called “cyanobacteria.” This seemingly invisible bacterium carried a type of machinery that could convert sunlight into oxygen. The explosion of oxygen into the atmosphere marked the initiation of life on the planet. Everything, from the rocky cliffs of mountains to the red sedimentary dunes to baboons and giant southern lizards, everything was born out of this one event.
A representative image of microbes.
During this event, scientists believe, the oxygen levels in the air rose dramatically from non-existent to 20% of what we breathe today, according to BBC Discover Wildlife. Ancient microbes were adapted to utilizing sulfate, nitrate, and ferric iron for respiration. But as oxygen erupted, the new organisms evolved with a different kind of physiological machinery, adapted to survive in high levels of oxygen. Lurking within the hot springs of Yellowstone National Park, the tiny microbes provide clues to this evolution.

Steam vents in Yellowstone supervolcano
For this study, scientists studied the microbes residing in streamers, thin, thread-like structures that sway in hot waters, similar to underwater plants. To investigate these filamentous microbes, scientists approached Lower Geyser Basin, Yellowstone’s largest geyser basin. The goal was to understand the role of oxygen, sulfur, and arsenic in energy conservation and community composition among these microbes. For more than 20 years, Professor Bill Inskeep from Montana State University (MSU) had been studying microbes living in Yellowstone’s hot springs.

The Octopus Spring in Yellowstone National Park.
For the latest research, he partnered with a colleague, Mensur Diakic, to unravel the mystery behind the GOE. They chose two hot springs from the park, namely Conch Spring and Octopus Spring. Given their similar geochemical profiles and subtle differences in oxygen levels, the microbial samples would provide an interesting glimpse into the past. Both springs had a water temperature that could rise to a blistering 190 degrees Fahrenheit, but Conch Spring had a lower level of oxygen than the Octopus Spring.

Conceptual illustration of microbes.
The microbes found in Conch were, therefore, some of the earliest, given their adaptability to low-oxygen environments, whereas the communities in Octopus Spring represented the organisms that likely arrived after the GOE. Thanks to Yellowstone’s enigmatic and assorted blend of atmospheric conditions, it became the perfect laboratory for scientists to study billions of years of evolution. "It would be very difficult to reproduce this kind of an experiment in the laboratory," Inskeep told the BBC. "Imagine trying to recreate hot-water streams with just the right amounts of oxygen and sulphide.”